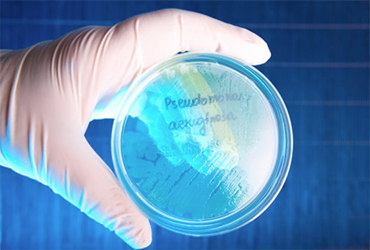

By IDSE News Staff
New findings challenge the traditional view that antimicrobial resistance (AMR) emerges from pathogens that acquire new mutations. Samples from ICU patients suggest instead, highly diverse pathogen communities harbor preexisting resistant genotypes. The results suggest that interventions aimed at limiting the spread of bacteria among patients may provide a powerful approach to combat AMR.
A study led by the University of Oxford provides new insight into how AMR emerges in patients with bacterial infections. The findings could help develop more effective interventions to prevent AMR infections developing in vulnerable patients (Nat Commun 2023;14[1]:4083).
The study’s findings challenge the traditional view that people are generally infected by a single genetic clone (or ‘strain’) of pathogenic bacteria, and that resistance to antibiotic treatment evolves because of natural selection for new genetic mutations that occur during the infection. Instead, these results suggest patients are commonly coinfected by multiple pathogen clones, with resistance emerging because of selection for preexisting resistant clones, rather than new mutations.
The researchers used a novel approach that examined changes in the genetic diversity and antibiotic resistance of Pseudomonas aeruginosa collected from patients before and after antibiotic treatment. The samples were isolated from 35 ICU patients in 12 European hospitals. P. aeruginosa is an opportunistic pathogen that is an important cause of hospital-acquired infections, particularly in immunocompromised and critically ill patients, and is thought to cause more than 550,000 deaths globally each year.
Each patient was screened for P. aeruginosa soon after being admitted to an ICU, with samples then collected at regular intervals thereafter. The researchers used a combination of genomic analyses and antibiotic challenge tests to quantify within-patient bacterial diversity and antibiotic resistance.
About two-thirds of the patients were infected by a single strain of P. aeruginosa. AMR evolved in some of these patients due to the spread of new resistance mutations that occurred during infection, supporting the conventional model of resistance acquisition. Surprisingly, the authors found that the remaining one-third of patients were infected by multiple strains of P. aeruginosa.
Crucially, resistance increased by about 20% more when patients with mixed-strain infections were treated with antibiotics, compared with those with single-strain infections. The rapid increase in resistance in patients with mixed-strain infections was driven by natural selection for preexisting resistant strains that were already present at the onset of antibiotic treatment. These strains usually made up a minority of the pathogen population that was present at the start of antibiotic treatment, but the antibiotic resistance genes they carried gave them a strong selective advantage under antibiotic treatment.
However, although AMR emerged more quickly in multi-strain infections, the findings suggest it may also be lost more rapidly in these conditions. When samples from single- and mixed-strain patients were cultured in the absence of antibiotics, the AMR strains grew more slowly compared with non-AMR strains. This supports the hypothesis that AMR genes carry fitness trade-offs, such that they are selected against when no antibiotics are present. These trade-offs were stronger in mixed-strain populations than in single-strain populations, suggesting that within-host diversity can also drive the loss of resistance in the absence of antibiotic treatment.
According to the researchers, the findings suggest that interventions aimed at limiting the spread of bacteria among patients, such as improved sanitation and infection control measures, may be a more effective intervention to combat AMR than interventions that aim to prevent new resistance mutations arising during infection, such as drugs that decrease the bacterial mutation rate. This is likely to be especially important when the infection rate is high, such as in immunocompromised patients.
The findings also suggest that clinical tests should move toward capturing the diversity of pathogen strains present in infections, rather than testing for only a small number of pathogen isolates, based on the assumption that the pathogen population is effectively clonal. This could enable more accurate predictions of whether antibiotic treatments will succeed or fail in individual patients, similar to how measurements of diversity in cancer cell populations can help predict the success of chemotherapy.
“The key finding of this study is that resistance evolves rapidly in patients colonized by diverse P. aeruginosa populations due to selection for preexisting resistant strains. The rate at which resistance evolves in patients varies widely across pathogens, and we speculate that high levels of within-host diversity may explain why some pathogens, such as Pseudomonas, rapidly adapt to antibiotic treatment,” said lead researcher Craig MacLean, PhD, from the Department of Biology at the University of Oxford, in England.
“The diagnostic methods that we use to study antibiotic resistance in patient samples have changed very slowly over time, and our findings underscore the importance of developing new diagnostic methods that will make it easier to assess the diversity of pathogen populations in patient samples,” he added.
The World Health Organization has declared AMR to be one of the top 10 global public health threats facing humanity. In 2019, AMR was associated with nearly 5 million deaths worldwide.
“Multidrug-resistant infections caused by a range of organisms including P. aeruginosa are a major challenge for patient management in ICU settings worldwide. The findings of this study add further evidence for the vital importance of infection prevention and control measures in ICUs and hospital settings more widely that reduce the risk of acquiring P. aeruginosa and other pathogenic organisms,” said Sharon Peacock, PhD, a professor of microbiology and public health at the University of Cambridge, in England, who was not directly involved with the study.




